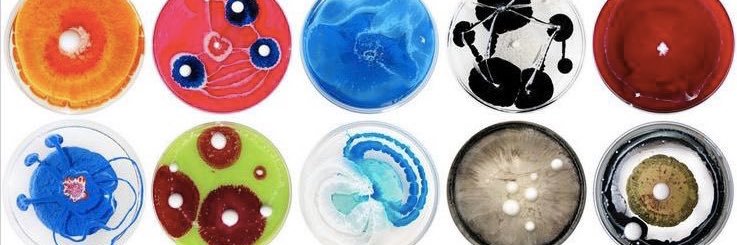
auntieee banner

Sabitlenmiş Tweet
auntieee
19.8K posts

@2mm2mm2mm2mm he loved that shit tho, remember when he moved to squidward paradise and hated it
English

she simply knows a great romantic comedy when she sees one luv her
Ara@lefilmara
Seeing this again and all 5 Twilight movies in one day is crazy 😭 like did she think Rob was going to quiz her about it on the first day of filming?? 😩
English
auntieee retweetledi
auntieee retweetledi

@nogumhundo no exactly i’ll leave a ngga if his ass crack is showing now idgaf
English
auntieee retweetledi

These mfs threw me a surprise party mane wow I love everybody
daisy@ihatedai
we ate this for the king @nogumhundo love u sm
English

they said ya next album gon sound like this
Jack Harlow@jackharlow
My new album is out now everywhere
English










